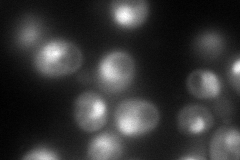
YOR362C
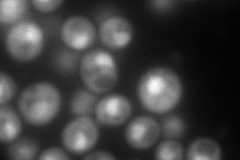
YOR362C

View description
Alpha 7 subunit of the 20S proteasome
Localization:
Intensity:
Fold change:
Significance:
-
C’ GFP library in SD

nucleus:cytosol134.26 -
N' NOP1pr-GFP in SD
nucleolus177.238 -
N' TEF2pr-mCherry in SD
nucleus188.902 -
N' NATIVEpr-GFP in SD

nucleus115.185 -
N' TEF2pr-VC and Cyto-VN in SD

cytosol,punctate46.7929 -
C’ GFP library in SD+DTT

nucleus.cytosol161.921.2No -
C’ GFP library in SD+H2O2

nucleus.cytosol135.81.01No -
C’ GFP library in Starvation Media

nucleus,cytosol159.531.18No -
C’ GFP library on the background of Pup2-DaMP

nucleus:cytosol -
C’ GFP library on the background of CCT mutant

nucleus:cytosol184.4731.37386Yes
